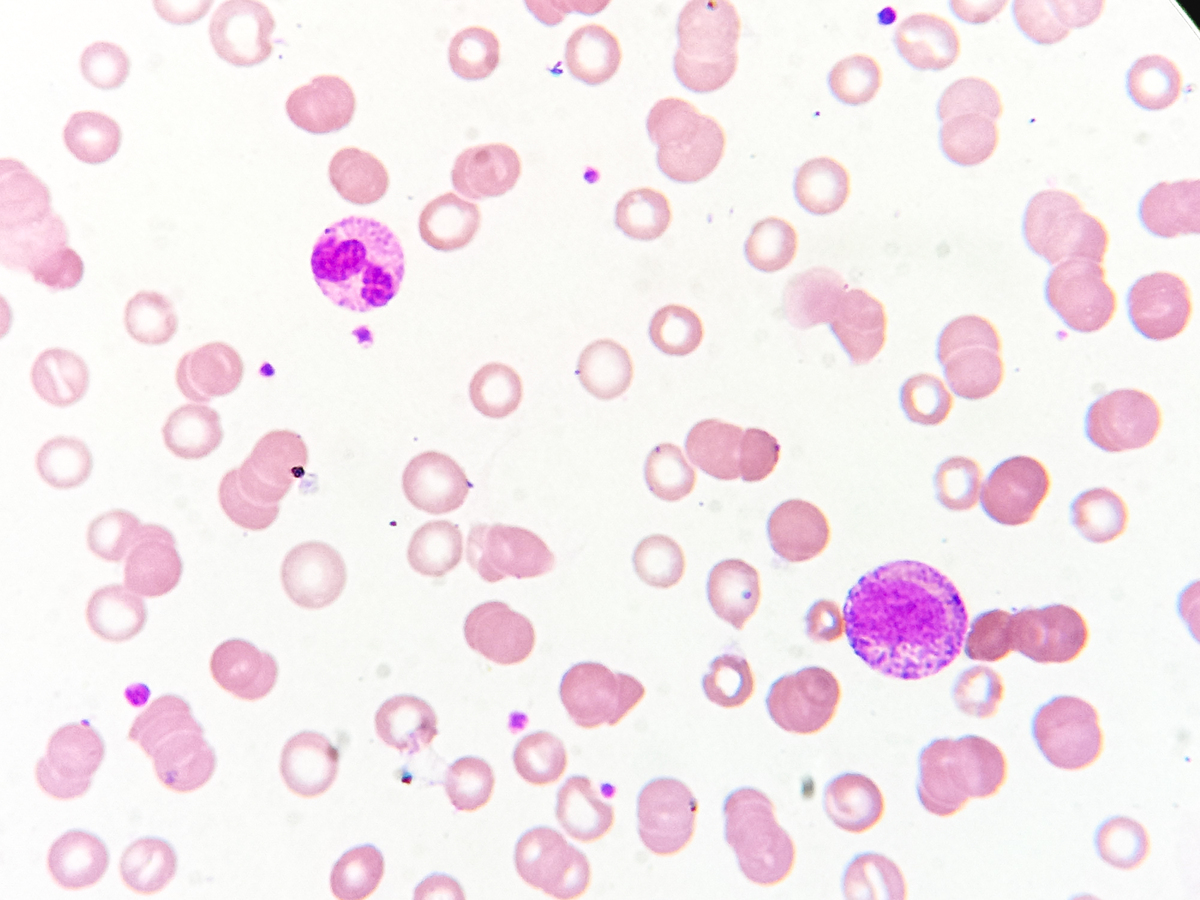
人体细胞平均重量是多少？不同类型细胞重量差异大

人体细胞平均重量是多少?不同类型细胞重量差异大
人体细胞平均重量是多少?不同类型细胞重量差异大
你是否想过人体细胞的平均重量是多少? 实际上,人体细胞的平均重量并非一成不变,它会根据细胞类型、大小和组成的不同而有所差异。
不同类型细胞的平均重量范围:
- 血红细胞(红细胞): 平均重量约为25-30纳克(ng)。2. 肌肉细胞: 平均重量范围较广,通常在1-100微克(μg)之间,具体取决于肌肉类型和大小。3. 脂肪细胞: 平均重量范围也较广,通常在10-100微克(μg)之间,具体取决于脂肪细胞的大小和脂肪含量。4. 神经细胞: 平均重量范围同样较广,通常在1-100微克(μg)之间,具体取决于神经细胞的类型和大小。
需要注意的是,以上数据仅为估计值,实际的细胞重量可能因个体差异、健康状况和其他因素而有所不同。
影响细胞重量的因素:
- 细胞类型: 不同类型的细胞具有不同的功能和结构,因此其大小和组成成分也不尽相同,导致重量差异。* 细胞大小: 即使是同类型的细胞,其大小也可能有所不同,例如肌肉细胞的大小就与其功能和训练程度有关。* 细胞组成成分: 细胞内的物质,如细胞器、细胞质和细胞外液等,都会影响细胞的重量。* 个体差异: 每个人的生理状况不同,细胞的重量也会有所差异。* 健康状况: 疾病或其他健康问题可能会影响细胞的大小和组成,进而影响其重量。
因此,以上列出的细胞平均重量只是一个大致的参考范围,实际情况可能会更加复杂。
原文地址: https://www.cveoy.top/t/topic/RNW 著作权归作者所有。请勿转载和采集!